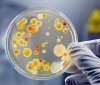
У 14 працівників дитячих їдалень Вінниччини виявили золотистий стафілокок

Дорожньо-транспортна пригода сталась 19 жовтня у Вінницькому районі за участі автомобілів Opel та Fiat. З тілесними ушкодженнями до медичних закладів потрапили пасажирки автомобіля Fiat. Поліція встановлює причини та обставини аварії.
 Автопригода сталась близько 19.20 години в місті Немирів. За інформацією слідства, внаслідок зіткнення двох транспортних засобів, постраждали 42-річна та 21-річна пасажирки Fiat.
Автопригода сталась близько 19.20 години в місті Немирів. За інформацією слідства, внаслідок зіткнення двох транспортних засобів, постраждали 42-річна та 21-річна пасажирки Fiat.
 Транспортні засоби поміщено на арештмайданчик.
Транспортні засоби поміщено на арештмайданчик.
Слідчий розпочав кримінальне провадження.